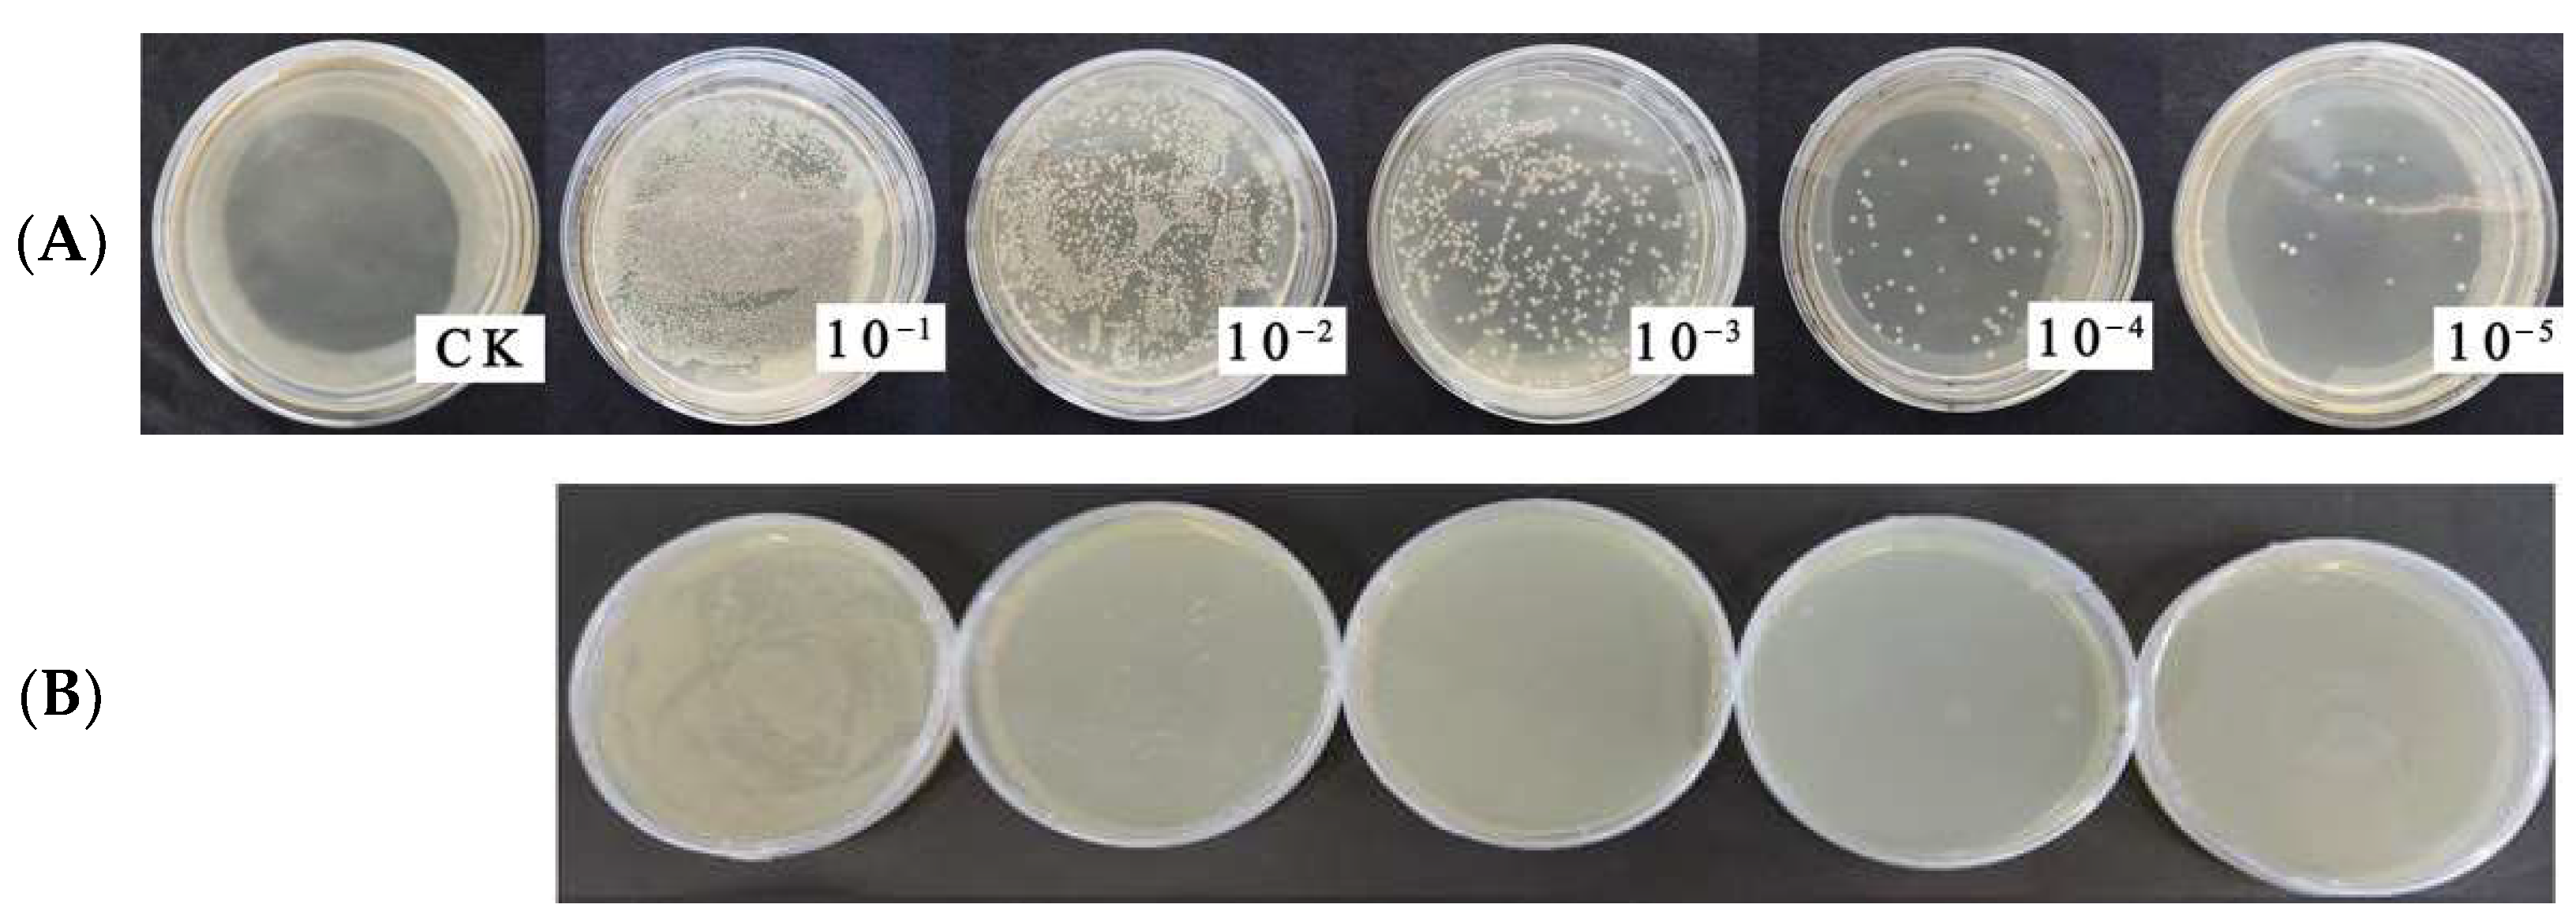
Agronomy 13 01228 g006 Agronomy 13 01228 g006
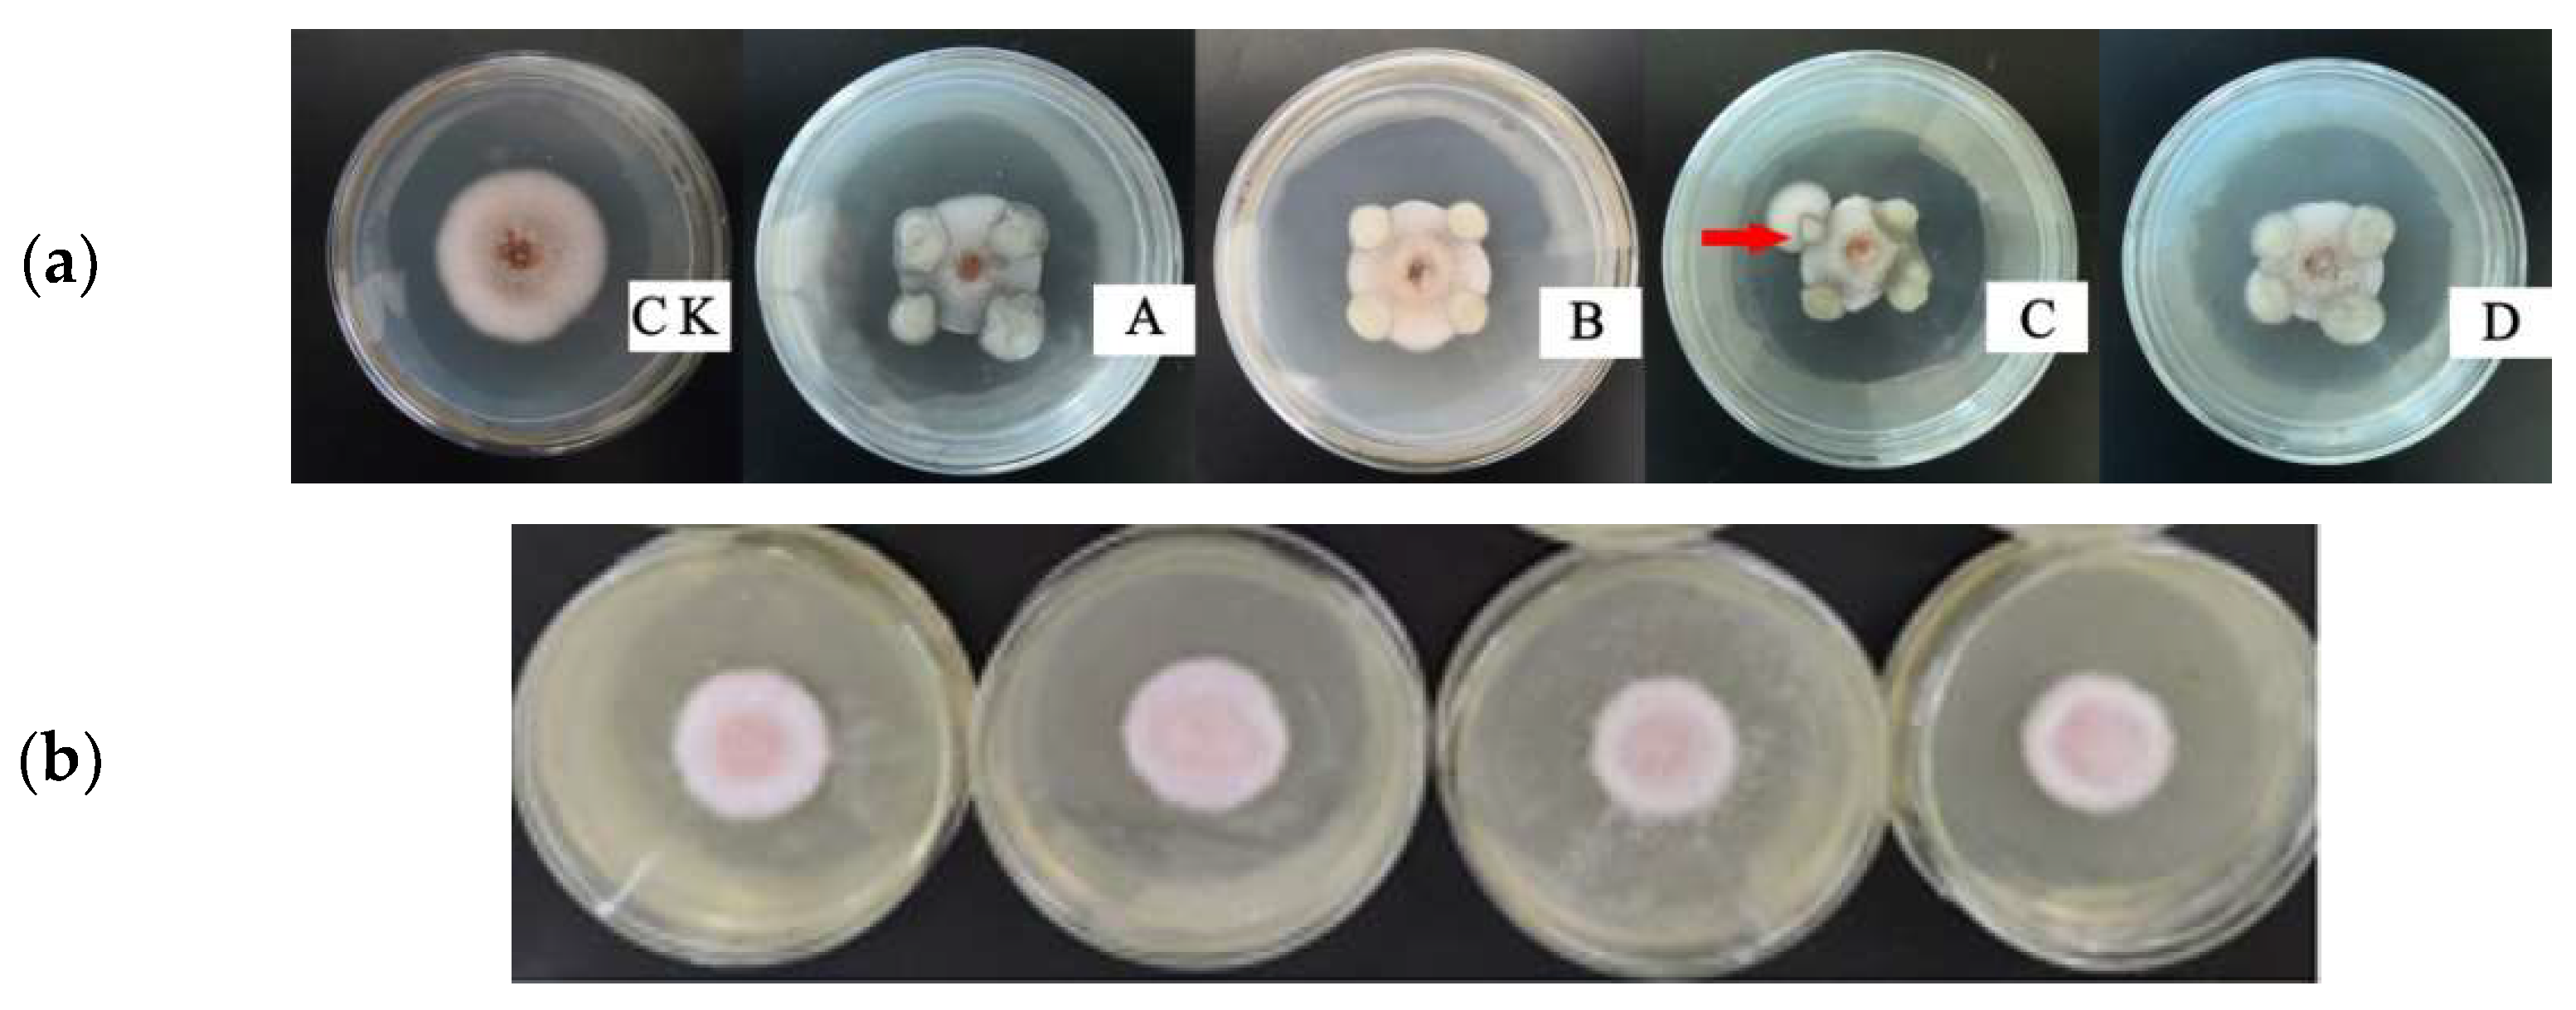
Agronomy 13 01228 g007 Agronomy 13 01228 g007

Hemp (Cannabis sativa L.) Interruption Cultivation Evidently Decreases the Anthracnose in the Succeeding Crop Chilli (Capsicum annuum L.)
Abstract
1. Introduction
2. Materials and Methods
2.1. Investigation of Chilli Anthracnose in the Fields of Continuous Chilli and Hemp-Chilli Rotation
2.2. Suppression of the Growth of Chilli Anthracnose Fungus by Plant Residue Extract
2.2.1. Preparation of Plant Residue Water Extract
2.2.2. Preparation of Spores’ Suspension of Chilli Anthracnose Fungus
2.2.3. Suppression of the Growth of Chilli Anthracnose Fungus by Plant Residue Extract
Inhibition of Spore Germination
Inhibition of Mycelia Growth
2.3. Isolation and Identification of Potential Antagonistic Bacteria from Plant Rhizosphere
2.3.1. Preparation of Rhizosphere Soil Suspension
2.3.2. Culture of Potential Antagonistic Bacteria from the Soil Suspension
2.3.3. Screening of the Antagonistic Bacteria
Preparation of Chilli Anthracnose Fungus
Test of Antagonistic Bacteria
Re-Test of the Antagonistic Bacteria
2.3.4. Suppression of the Growth of Chilli Anthracnose Fungus by the Selected Antagonistic Bacteria
2.3.5. Identification of the Antagonistic Bacteria Based on 16SrDNA Sequence
2.4. Data Collection and Analysis
3. Results
3.1. Effect of Hemp Cultivation on the Incidence of Anthracnose Disease of Succeeding Chilli
3.2. Effect of Hemp and Chilli Extract on Spore Germination of the Anthracnose Fungus
3.3. Effect of Hemp and Chilli Extract on Mycelia Growth of the Anthracnose Fungus
3.4. Antagonistic Bacteria of the Anthracnose Fungus Isolated from Hemp Rhizosphere Soil
3.4.1. The Isolated Antagonistic Bacteria
3.4.2. Identification of the Antagonistic Bacteria Based on DNA Sequence
3.4.3. Inhibition of the Isolated Antagonistic Bacteria on Growth of the Anthracnose Fungus
4. Discussion
5. Conclusions
Author Contributions
Funding
Data Availability Statement
Acknowledgments
Conflicts of Interest
References
- Li, Q.; Han, Y.-Z.; Zhang, G.-C. Status and development trends of hot pepper industry in China and abroad. Hubei Agric. Sci. 2009, 48, 2278–2281. [Google Scholar]
- Wilson, M.J.; Maliszewska-Kordybach, B. (Eds.) Soil Quality, Sustainable Agriculture and Environmental Security in Central and Eastern Europe; Springer: Berlin/Heidelberg, Germany, 2000; Volume 69, pp. 776–778. [Google Scholar]
- Meyer, W.B.; Turner, B.L. Human population growth and global land-use/cover change. Annu. Rev. Ecol. Syst. 1992, 23, 39–61. [Google Scholar] [CrossRef]
- Li, Y. Isolation of Colletotrichum Strains from Pepper Anthracnose and Screening of Pepper (Capsicum annuum) Mutants Resistance to Colletotrichum; Huazhong Agricultural University: Wuhan, China, 2019. [Google Scholar]
- Xiangping, Z.; Zhixiang, Z.; Meiying, F.; Huifang, W.; Shu, H.; Min, X. Identification of pepper anthracnose pathogen in Hainan province and analysis on its sensitivity to azoxystrobin. China Plant Prot. 2016, 36, 5–8. [Google Scholar]
- Geng, G.; Yang, R.-R.; Yu, L.-H.; Lv, C.-H.; Li, R.-R.; Wang, Y.-G. Crop Continuous Cropping Obstacles: Research Progress. Chin. Agric. Sci. Bull. 2019, 35, 36–42. [Google Scholar]
- Guo, X.-D. The continuous obstacle and its prevention in the soil of green house. Gansu Agric. Sci. Technol. 2003, 7, 38–40. [Google Scholar]
- Xu, R.-F.; Ren, Y.-X. Effect of peanut continuous cropping on soil microbiological population. Syst. Sci. Compr. Stud. Agric. 2003, 19, 33–34. [Google Scholar]
- Wu, Y.-F.; Zhang, X.-Y.; Li, Y.; Wei, W.-J.; Gao, L.-H. Influence of rotation on continuous cropping soil environment and cucumber yield. Acta Hortic. Sin. 2008, 35, 357–362. [Google Scholar]
- Zhang, H.-Y.; Yang, W.-F. Effect of cucumbers and red peppers-rice rotation mode on continuous dropping obstacles. J. Guangxi Agric. 2017, 32, 9–13. [Google Scholar]
- Latif, S.; Chiapusio, G.; Weston, L.A. Chapter Two—Allelopathy and the Role of Allelochemicals in Plant Defence. In Advances in Botanical Research; Becard, G., Ed.; Academic Press: Cambridge, MA, USA, 2017; Volume 82, pp. 19–54. [Google Scholar]
- Yamamoto, S.; Shiraishi, S.; Kawagoe, Y.; Mochizuki, M.; Suzuki, S. Impact of Bacillus amyloliquefaciens S13-3 on control of bacterial wilt and powdery mildew in tomato. Pest Manag. Sci. 2015, 71, 722–727. [Google Scholar] [CrossRef]
- Liu, F.-H.; Hu, H.-R.; Du, G.-H.; Deng, G.; Yang, Y. Ethnobotanical research on origin, cultivation, distribution and utilization of hemp (Cannabis sativa L.) in China. Indian J. Tradit. Knowl. 2017, 16, 235–242. [Google Scholar]
- Gorchs, G.; Lloveras, J.; Serrano, L.; Cela, S. Hemp yields and its rotation effects on wheat under rainfed Mediterranean conditions. Agron. J. 2017, 109, 1551–1560. [Google Scholar] [CrossRef]
- Zhang, Q.Y.; Li, Z.L.; Han, B.J.; Zhou, K.Q.; Zhang, X.Y.; Hashemi, M.; Liu, X.B. Immediate responses of cyst nematode, soil-borne pathogens and soybean yield to one-season crop disturbance after continuous soybean in northeast China. Int. J. Plant Prod. 2013, 7, 341–353. [Google Scholar]
- Yu, R.; Ma, Y.-Q. Melon broomrape and sunflower broomrape seeds germination induced by hemp (Cannabis sativa L.) plants. J. China Agric. Univ. 2014, 19, 38–46. [Google Scholar]
- Xia, R.-Z.; Xie, Y.; Yin, W.; Zhang, Y.; Liao, X.-L. Extraction and antibacterial activity of active substances from Amaranthus tricolor. China Veg. 2015, 8, 49–53. [Google Scholar]
- Zhao, N. The Regulation of Rotation Cropping Three Kinds of Solanaceous Vegetables to the Soil Microbes from Severe Fusarium Wilt Banana Field; Hainan University: Haikou, China, 2014. [Google Scholar]
- Hao, W.-Y. Effects of Allelochemicals from Watermelon and Rice Root Exudates on Fusarium Wilt of Watermelon; Nanjing Agricultural University: Nanjing, China, 2010. [Google Scholar]
- Wu, F.-Z.; Meng, L.-J.; Wen, J.-Z. Effect of root exudate on mycelium growth of cucumber Fusarium wilt. China Veg. 2002, 5, 26–27. [Google Scholar]
- Zhang, Q.; Liang, Y.-Y.; Hu, W.-W.; Yang, X.-Y.; Li, J.-Y.; He, H.-B. Screening the bacteria herbicide from the rhizosphere soils of allelopathic rice. Chin. Agric. Sci. Bull. 2015, 31, 170–174. [Google Scholar]
- Zhan, F.-Q.; Hou, X.-Q.; Yang, W.-Q.; Yang, R.; Hou, M.; Zhang, H.-T.; Long, X.-Q.; Cui, W.-D. Isolation and identification of antagonistic bacteria against Fusarium wilt tomato. XinJiang Agric. Sci. 2011, 48, 1649–1654. [Google Scholar]
- Yoon, S.H.; Ha, S.M.; Kwon, S.; Lim, J.; Kim, Y.; Seo, H.; Chun, J. Introducing EzBioCloud: A taxonomically united database of 16S rRNA and whole genome assemblies. Int. J. Syst. Evol. Microbiol. 2017, 67, 1613–1617. [Google Scholar] [CrossRef]
- Tamura, K.; Stecher, G.; Kumar, S. MEGA 11: Molecular Evolutionary Genetics Analysis Version 11. Mol. Biol. Evol. 2021, 38, 3022–3027. [Google Scholar] [CrossRef]
- Tang, Q.-Y.; Zhang, C.-X. Data Processing System (DPS) software with experimental design, statistical analysis and data mining developed for use in entomological research. Insect Sci. 2013, 20, 254–260. [Google Scholar] [CrossRef]
- Passari, A.K.; Mishra, V.K.; Saikia, R.; Gupta, V.K.; Singh, B.P. Isolation, abundance and phylogenetic affiliation of endophytic actinomycetes associated with medicinal plants and screening for their in vitro antimicrobial biosynthetic potential. Front. Microbiol. 2015, 6, 1–13. [Google Scholar] [CrossRef]
- Hickman, D.A.-O.; Rasmussen, A.; Ritz, K.; Birkett, M.A.-O.; Neve, P.A.-O. Review: Allelochemicals as multi-kingdom plant defence compounds: Towards an integrated approach. Pest Manag. Sci. 2021, 77, 1121–1131. [Google Scholar] [CrossRef]
- Schalchli, H.; Pardo, F.; Hormazabal, E.; Palma, R.; Guerrero, J.; Bensch, E. Antifungal activity of wheat root exudate extracts on Gaeumannomyces graminis var. Tritici growth. J. Soil Sci. Plant Nutr. 2012, 12, 329–337. [Google Scholar] [CrossRef]
- Goswami, B.K.; Vijaylakshmi, K. Effect of some indigenous plant materials and oil-cake amended soil on the growth of tomato and root-knot nematode population. Ann. Agric. Res. 1986, 7, 363–366. [Google Scholar]
- Feng, Y.-T.; Xie, Y.; Zhang, Y.; Liao, X.-L. Inhibition activity of Capsella bursa-pastoris extracts against Ralstonia solanacearum. J. Hunan Agric. Univ. (Nat. Sci.) 2016, 42, 312–316. [Google Scholar]
- Schrey, S.D.; Tarkka, M.T. Friends and foes: Streptomycetes as modulators of plant disease and symbiosis. Antonie Van Leeuwenhoek 2008, 94, 11–19. [Google Scholar] [CrossRef]
- Kinkel, L.L.; Schlatter, D.C.; Bakker, M.G.; Arenz, B.E. Streptomyces competition and co-evolution in relation to plant disease suppression. Res. Microbiol. 2012, 163, 490–499. [Google Scholar] [CrossRef]
- Thilagam, R.; Hemalatha, N. Plant growth promotion and chilli anthracnose disease suppression ability of rhizosphere soil actinobacteria. J. Appl. Microbiol. 2019, 126, 1835–1849. [Google Scholar] [CrossRef]
- Jin, F.; Ding, Y.; Ding, W.; Reddy, M.S.; Fernando, W.G.D.; Du, B. Genetic Diversity and Phylogeny of Antagonistic Bacteria against Phytophthora nicotianae Isolated from Tobacco Rhizosphere. Int. J. Mol. Sci. 2011, 12, 3055–3071. [Google Scholar] [CrossRef]
- Smarda, J.; Smajs, D.; Lhotova, H.; Dedicova, D. Occurrence of strains producing specific antibacterial inhibitory agents in five Genera of Enterobacteriaceae. Curr. Microbiol. 2007, 54, 113–118. [Google Scholar] [CrossRef]
- Ongena, M.; Jacques, P. Bacillus lipopeptides: Versatile weapons for plant disease biocontrol. Trends Microbiol. 2008, 16, 115–125. [Google Scholar] [CrossRef]
- Li, J.; Hu, M.; Xue, Y.; Chen, X.; Lu, G.; Zhang, L.; Zhou, J. Screening, Identification and Efficacy Evaluation of Antagonistic Bacteria for Biocontrol of Soft Rot Disease Caused by Dickeya zeae. Microorganisms 2020, 8, 697. [Google Scholar] [CrossRef]
- Hossain, A.; Ali, M.A.; Lin, L.; Luo, J.; You, Y.; Masum, M.M.I.; Jiang, Y.; Wang, Y.; Li, B.; An, Q. Biocontrol of Soft Rot Dickeya and Pectobacterium Pathogens by Broad-Spectrum Antagonistic Bacteria within Paenibacillus polymyxa Complex. Microorganisms 2023, 11, 817. [Google Scholar] [CrossRef]

| Code of AB | GenBank Accession Number | Taxon of the Strains | Sequence Similarity (%) |
|---|---|---|---|
| 1 | OQ847981 | Enterobacter sichuanensis | 99.86 |
| 2 | OQ847982 | Enterobacter sichuanensis | 99.74 |
| 3 | OQ847983 | Enterobacter sichuanensis | 99.63 |
| 4 | OQ847984 | Enterobacter sichuanensis | 99.74 |
| 5 | OQ847985 | Enterobacter sichuanensis | 99.74 |
| 6 | OQ847986 | Enterobacter sichuanensis | 99.74 |
| 7 | OQ847987 | Enterobacter sichuanensis | 100.00 |
| 8 | OQ847988 | Enterobacter sichuanensis | 100.00 |
| 9 | OQ847989 | Enterobacter sichuanensis | 99.86 |
| 10 | OQ847990 | Enterobacter sichuanensis | 100.00 |
| 11 | OQ847991 | Enterobacter sichuanensis | 99.86 |
| 12 | OQ847992 | Enterobacter sichuanensis | 100.00 |
| 13 | OQ847993 | Enterobacter sichuanensis | 100.00 |
| 14 | OQ847994 | Enterobacter sichuanensis | 100.00 |
| 15 | OQ847995 | Enterobacter sichuanensis | 100.00 |
Disclaimer/Publisher’s Note: The statements, opinions and data contained in all publications are solely those of the individual author(s) and contributor(s) and not of MDPI and/or the editor(s). MDPI and/or the editor(s) disclaim responsibility for any injury to people or property resulting from any ideas, methods, instructions or products referred to in the content. |
© 2023 by the authors. Licensee MDPI, Basel, Switzerland. This article is an open access article distributed under the terms and conditions of the Creative Commons Attribution (CC BY) license (https://creativecommons.org/licenses/by/4.0/).
Share and Cite
Liu, F.; Li, X.; Hu, H.; Li, J.; Du, G.; Yang, Y.; Tang, K.; Li, E.; Li, H.; Chen, L. Hemp (Cannabis sativa L.) Interruption Cultivation Evidently Decreases the Anthracnose in the Succeeding Crop Chilli (Capsicum annuum L.). Agronomy 2023, 13, 1228. https://doi.org/10.3390/agronomy13051228
Liu F, Li X, Hu H, Li J, Du G, Yang Y, Tang K, Li E, Li H, Chen L. Hemp (Cannabis sativa L.) Interruption Cultivation Evidently Decreases the Anthracnose in the Succeeding Crop Chilli (Capsicum annuum L.). Agronomy. 2023; 13(5):1228. https://doi.org/10.3390/agronomy13051228
Chicago/Turabian StyleLiu, Feihu, Xuan Li, Huaran Hu, Jiaonan Li, Guanghui Du, Yang Yang, Kailei Tang, E Li, Huiping Li, and Li Chen. 2023. "Hemp (Cannabis sativa L.) Interruption Cultivation Evidently Decreases the Anthracnose in the Succeeding Crop Chilli (Capsicum annuum L.)" Agronomy 13, no. 5: 1228. https://doi.org/10.3390/agronomy13051228
APA StyleLiu, F., Li, X., Hu, H., Li, J., Du, G., Yang, Y., Tang, K., Li, E., Li, H., & Chen, L. (2023). Hemp (Cannabis sativa L.) Interruption Cultivation Evidently Decreases the Anthracnose in the Succeeding Crop Chilli (Capsicum annuum L.). Agronomy, 13(5), 1228. https://doi.org/10.3390/agronomy13051228

